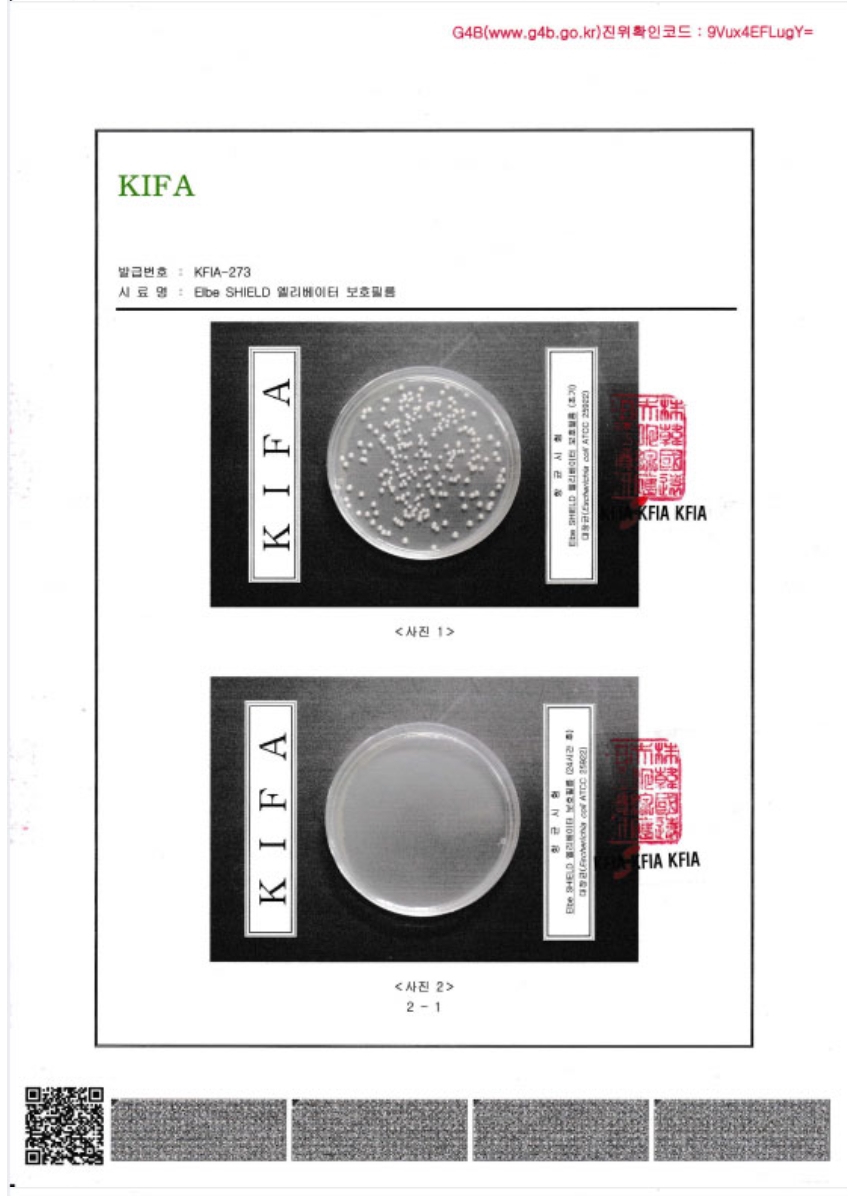
시험성적서 3-2

팝업레이어 알림
팝업레이어 알림이 없습니다.
사이트 정보
회사명 : 회사명 / 대표 : 대표자명
주소 : OO도 OO시 OO구 OO동 123-45
사업자 등록번호 : 123-45-67890
전화 : 02-123-4567 팩스 : 02-123-4568
통신판매업신고번호 : 제 OO구 - 123호
개인정보관리책임자 : 정보책임자명
접속자집계
- 오늘
- 16
- 어제
- 28
- 최대
- 113
- 전체
- 847
Copyright © 소유하신 도메인. All rights reserved.